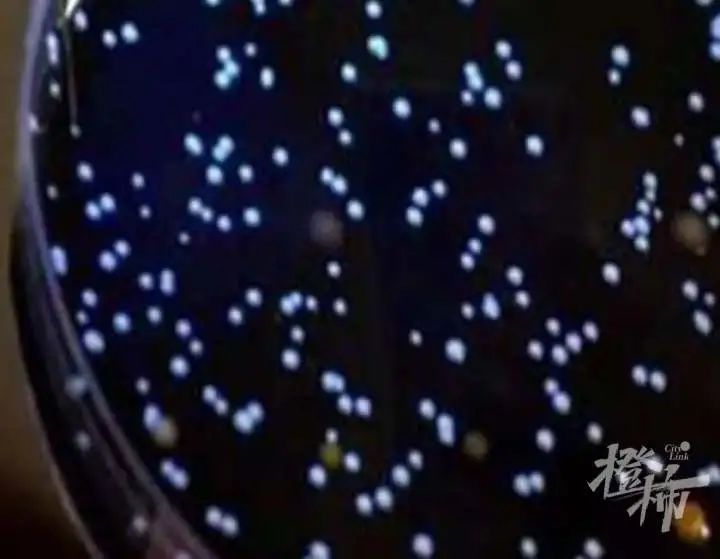
致病菌|警惕！37岁男子吹空调住进ICU！住了一周未脱险
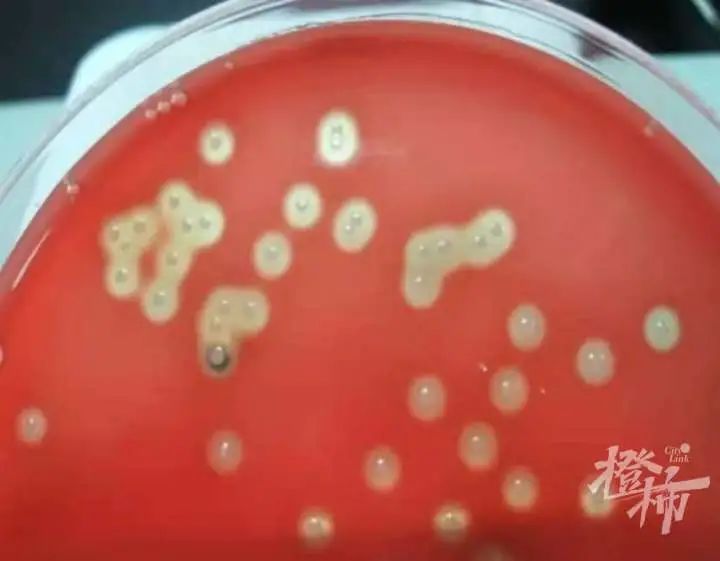
致病菌|警惕！37岁男子吹空调住进ICU！住了一周未脱险

近日,37岁的李先生在ICU住了一周尚未脱险,身边的ECMO、血透机、呼吸机正24小时运转,医生的诊断结果是军团菌感染。
原来,一周前天气炎热,很久没用的空调派上了用场,谁知这一吹就吹进了ICU。
文章插图
其实,一段时间未用的空调,需要彻底清洗,达到国家卫生标准后方可继续使用。中国疾病预防控制中心相关研究显示,部分受调查家用空调中的细菌总数、真菌总数均超过国家相关卫生标准数倍。根据WS394-2012《公共场所集中空调卫生规范》要求,每立方米细菌总数、真菌总数均需小于500CFU,不得检出嗜肺军团菌及β-溶血性链球菌。
嗜肺军团菌常从空调冷却水、热水器水等与人群密切接触水体以气溶胶的形式经呼吸道传播给人,尤其是老年人、免疫功能缺陷或低下的患者、吸烟者和慢性呼吸道疾病患者。当带菌的气溶胶到达人体呼吸道时,可感染肺泡巨噬细胞, 导致以肺部感染为主同时伴有全身多系统损害的急性重症肺炎,即军团菌病。
文章插图
β-溶血性链球菌是引起咽峡炎、急性扁桃体炎等上呼吸道感染最常见的致病菌之一,也可引起其他感染性疾病如脓皮病、坏死性筋膜炎、脓毒休克综合征,少数患者在感染后出现自身免疫性疾病如急性肾炎、风湿热或风湿性心脏病等。
文章插图
致病菌虽然可怕,但是不用慌,做好空调清洁就可以有效避免其侵染。一段时间未用的空调,使用前需彻底清洗。
以下清洁步骤适合顶挂、壁挂或立式空调:
1.关电源,拔插头,用不滴水的湿布擦拭空调外壳和裸露的塑料外件。
2.取出过滤网,用消毒剂浸泡后冲洗。
3.取出空气净化过滤器,露出散热片。
4.将空调清洗剂离散热片5cm,从上到下喷洗整个散热片。
5.等待15分钟,将过滤器和过滤网装上。
6.重新开机,制冷15-30分钟,污水会自动从排水管排出。
对于消毒剂的选择,应选用专业的品牌、有卫生部门“消”字号的空调消毒剂,或使用250mg/L-500mg/L含氯(溴)消毒液,进行喷洒、浸泡或擦拭,作用10-30分钟。对于需要消毒的金属部件,建议优先选用季铵盐类消毒剂。对于商场、酒店、车站、办公楼及其他公共场所的中央空调,建议委托具有专业资质的第三方机构进行清洗。
眼看辽宁人的空调
也要用起来了,
趁着这几天还不算热,
赶紧把家里的空调清洗一下吧!
【 致病菌|警惕!37岁男子吹空调住进ICU!住了一周未脱险】来源:都市快报
- 新冠病毒|警惕!刚刚通报:又一地出现奥密克戎
- 张女士|警惕无痛血尿 别让癌症找上门
- 余姚市|警惕!这类疾病是老年人的“沉默”杀手,髋部骨折后致死率高达20%
- 肠镜检查|关注肛肠健康,警惕肛周湿疹样癌
- 红灯|肠道出问题后,身体会有3个表现,若你有,警惕肠道亮“红灯”了
- 饮酒|经常不受控制的眼皮跳不“单纯”,警惕面肌痉挛找上门
- 中毒|警惕!厦门、漳浦近期已有2人中毒,都是因为它!这种吃法要不得!
- 这种东西别碰!漳州又有人中招......|千万警惕 | 乔迁
- 核桃|每天一包坚果,竟吃出高血脂!坚果到底怎么吃?还需警惕三种会伤身的坚果
- 调理|颈部大椎穴不通时,警惕心脑血管“亮红灯”,若你有,尽快调理
